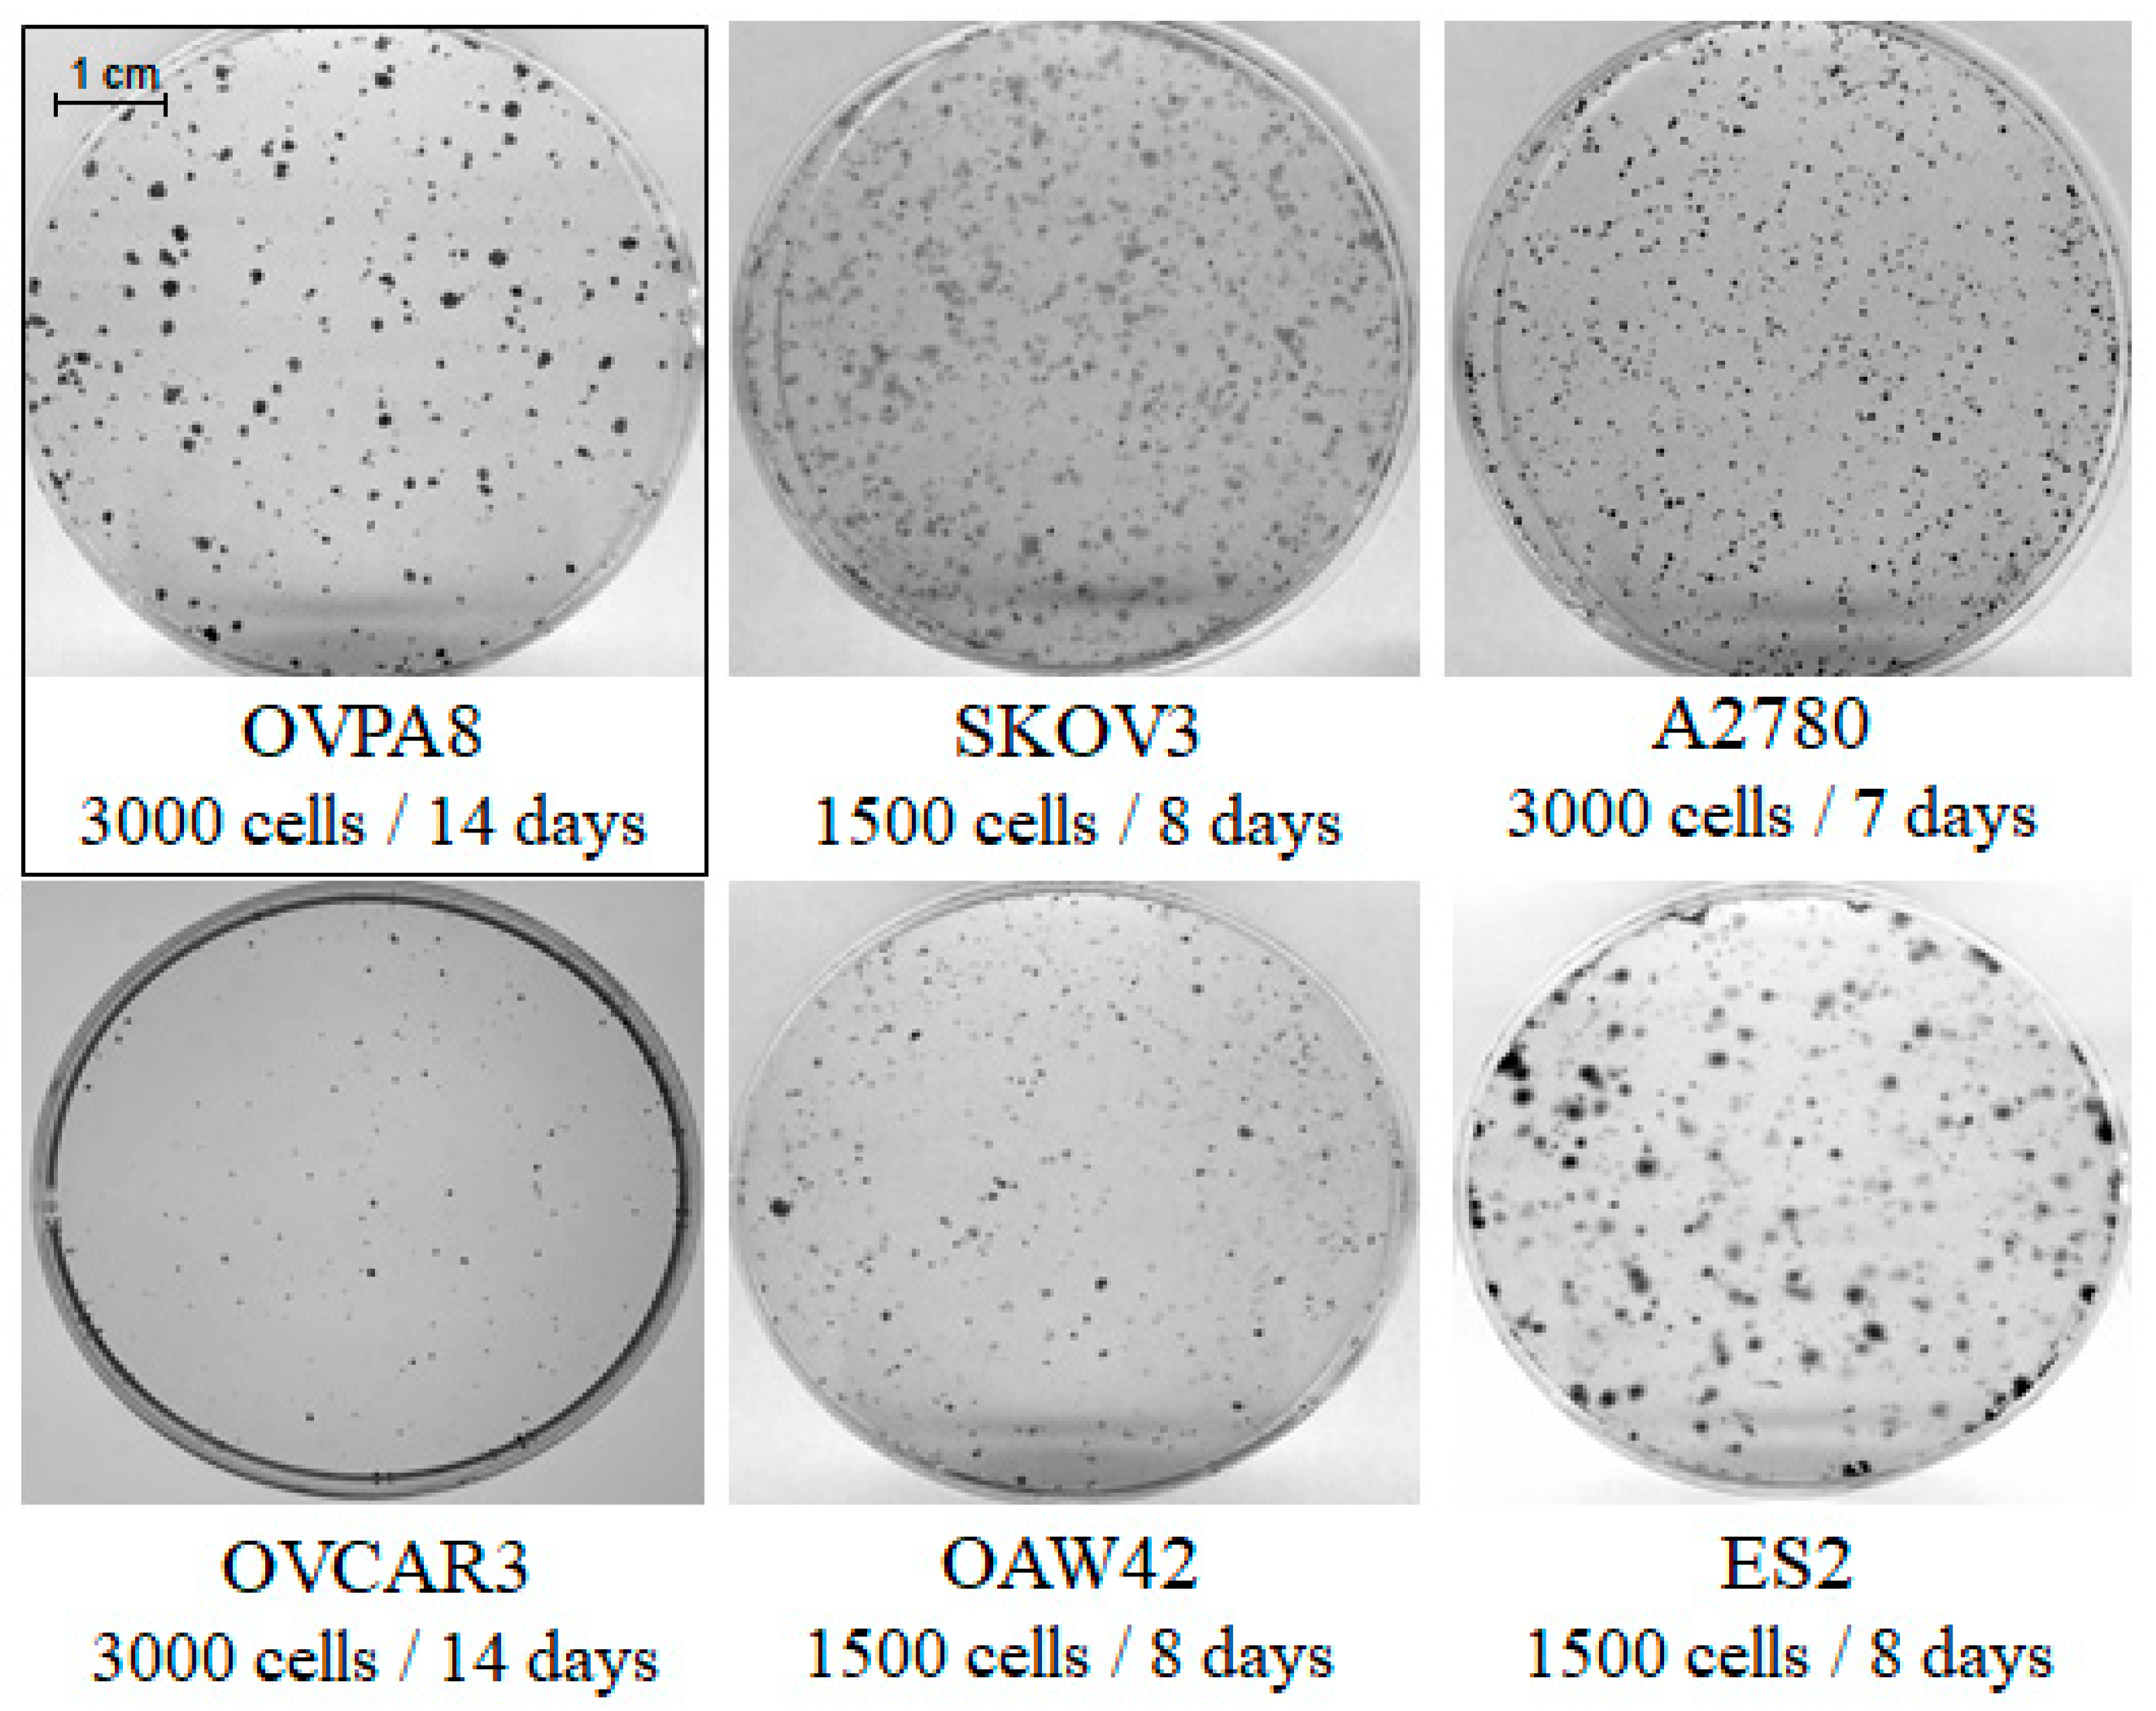
Ijms 19 02080 g005

Establishment and Characterization of the Novel High-Grade Serous Ovarian Cancer Cell Line OVPA8
Abstract
1. Introduction
2. Results
2.1. Patient History
2.2. Establishment of Cell Line Form a High-Grade Serous Ovarian Cancer
2.3. Cell Growth, Morphology and Cytogenetic Characteristics
2.4. Microbiological Analysis and Biosafety
2.5. Mutation Profile of OVPA8 Cell Line
2.6. Migration and Invasiveness of OVPA8 Cells
2.7. Immunophenotypic Characterization of Ovarian Cancer Cell Lines
2.8. Evaluation of Cancer Stem-Like Cell Markers
2.9. Response to Anticancer Drugs
2.10. Expression of Potential Prognostic Markers in OVPA8 Cell Line
3. Discussion
3.1. Ovarian Cancer Is a Heterogeneous Disease
3.2. Uncertainty of Cellular Models of Ovarian Cancer
3.3. Stability of Cellular Models
3.4. Cellular Models of HGSOC
4. Materials and Methods
4.1. Establishment and Maintenance of the Cell Line from Malignant Ascites
4.2. Cell Lines and Culture Conditions
4.3. Detection of Virus Contamination
4.4. Detection of Mycoplasma Contamination
4.5. Cell’s Morphology and Growth Characteristics
4.6. Growth Curves and Chemosensitivity Assay
4.7. Short Tandem Repeat (STR) Analysis
4.8. Immunocytochemical Staining (ICC)
4.9. FACS Analysis
4.10. Karyotype Analysis
4.11. Mutation Testing
4.12. Semi-Quantitative Reverse-Transcription PCR (RT-PCR)
4.13. Western Blot Analysis
4.14. Statistical Analysis
Supplementary Materials
Author Contributions
Funding
Acknowledgments
Conflicts of Interest
Abbreviations
| ATCC | American Type Culture Collection |
| B2M | β-2-Microglobulin |
| BSL | Biosafety level |
| BNIP3 | BCL2-interacting protein 3 |
| CCLE | Cancer cell line encyclopedia |
| CC | Clear cell (ovarian cancer) |
| CGH | Comparative genome hybridization |
| CK19 | Luminal cytokeratin 19 |
| CT | Computed tomography |
| DT | Doubling time |
| EBV | Epstein-Barr virus |
| ECACC | European Collection of Authenticated Cell Cultures |
| E | Endometroid (ovarian cancer) |
| EpCAM | Epithelial cell adhesion molecule |
| FACS | Fluorescence-activated cell sorting |
| FGFR | Fibroblast growth factor receptor |
| FISH | Fluorescence in situ hybridization |
| FN1 | Fibronectin 1 |
| HBME-1 | Hector Battifora mesothelial epitope 1 |
| HBV | Hepatitis B virus |
| HCV | Hepatitis C virus |
| HE | Hematoxylin-eosin staining |
| HGSOC | High-grade serous ovarian cancer |
| HIV | Human immunodeficiency virus |
| ICC | Immunocytochemistry |
| IP | Intraperitoneal (chemotherapy) |
| ISCN | International System for Human Cytogenetic Nomenclature |
| IV | Intravenous (chemotherapy) |
| LGSOC | Low-grade serous ovarian carcinoma |
| NGS | New generation sequencing |
| OS | Overall survival |
| OSE | Ovarian surface epithelium |
| PAX8 | Paired Box 8 |
| POSTN | Periostin |
| PVDF | Polyvinylidene difluoride |
| RT-PCR | Reverse-transcription polymerase chain reaction |
| SD | Standard deviation |
| SDS-PAGE | Sodium dodecyl sulfate–polyacrylamide gel electrophoresis |
| SNP | Single nucleotide polymorphism |
| SP | Side population |
| STR | Short tandem repeat |
References
- National Cancer Institute: Cell Lines in the In Vitro Screen. Available online: https://dtp.cancer.gov/discovery_development/nci-60/cell_list.htm (accessed on 1 June 2018).
- Ellison, G.; Klinowska, T.; Westwood, R.F.R.; Docter, E.; French, T.; Fox, J.C. Further evidence to support the melanocytic origin of MDA-MB-435. J. Clin. Pathol. Mol. Pathol. 2002, 55, 294–299. [Google Scholar] [CrossRef]
- Rae, J.M.; Creighton, C.J.; Meck, J.M.; Haddad, B.R.; Johnson, M.D. MDA-MB-435 cells are derived from M14 melanoma cells—A loss for breast cancer, but a boon for melanoma research. Breast Cancer Res. Treat. 2007, 104, 13–19. [Google Scholar] [CrossRef] [PubMed]
- Chambers, A.F. MDA-MB-435 and M14 Cell Lines: Identical but not M14 Melanoma? Cancer Res. 2009, 69, 5292–5293. [Google Scholar] [CrossRef] [PubMed]
- Roschke, A.V.; Tonon, G.; Gehlhaus, K.S.; McTyre, N.; Bussey, K.J.; Lababidi, S.; Scudiero, D.A.; Weinstein, J.N.; Kirsch, I.R. Karyotypic complexity of the NCI-60 drug-screening panel. Cancer Res. 2003, 63, 8634–8647. [Google Scholar] [PubMed]
- Gartler, S.M. Apparent Hela Cell Contamination of Human Heteroploid Cell Lines. Nature 1968, 217, 750–751. [Google Scholar] [CrossRef] [PubMed]
- Fogh, J.; Wright, W.C.; Loveless, J.D. Absence of Hela-Cell Contamination in 169 Cell Lines Derived from Human Tumors. J. Natl. Cancer Inst. 1977, 58, 209–214. [Google Scholar] [CrossRef] [PubMed]
- Cobb, L.P.; Gaillard, S.; Wang, Y.; IeM, S.; Secord, A.A. Adenocarcinoma of Mullerian origin: Review of pathogenesis, molecular biology, and emerging treatment paradigms. Gynecol. Oncol. Res. Pract. 2015, 2, 1–16. [Google Scholar] [CrossRef] [PubMed]
- Kujawa, K.A.; Lisowska, K.M. Ovarian cancer—From biology to clinic. Postep. Hig. Med. Dosw. 2015, 69, 1275–1290. [Google Scholar] [CrossRef]
- Beaufort, C.M.; Helmijr, J.C.A.; Piskorz, A.M.; Hoogstraat, M.; Ruigrok-Ritstier, K.; Besselink, N.; Murtaza, M.; van IJcken, W.F.J.; Heine, A.A.J.; Smid, M.; et al. Ovarian Cancer Cell Line Panel (OCCP): Clinical Importance of In Vitro Morphological Subtypes. PLoS ONE 2014, 9, e103988. [Google Scholar] [CrossRef] [PubMed]
- Domcke, S.; Sinha, R.; Levine, D.A.; Sander, C.; Schultz, N. Evaluating cell lines as tumour models by comparison of genomic profiles. Nat. Commun. 2013, 4, 1–10. [Google Scholar] [CrossRef] [PubMed]
- Langdon, P.S.; Lawrie, S.S. Establishment of ovarian cancer cell lines. In Ovarian Cancer. Methods and Protocols; Bartlett, J.M.S., Ed.; Humana Press: Totowa, NJ, USA, 2000; pp. 155–159. [Google Scholar]
- Antoun, S.; Atallah, D.; Tahtouh, R.; Alaaeddine, N.; Moubarak, M.; Khaddage, A.; Ayoub, E.N.; Chahine, G.; Hilal, G. Different TP53 mutants in p53 overexpressed epithelial ovarian carcinoma can be associated both with altered and unaltered glycolytic and apoptotic profiles. Cancer Cell Int. 2018, 18, 1–10. [Google Scholar] [CrossRef] [PubMed]
- NCBI ClinVar Database: NM_000546.5(TP53):c.733G>A (p.Gly245Ser). Available online: https://www.ncbi.nlm.nih.gov/clinvar/variation/12365/ (accessed on 1 June 2018).
- Anglesio, M.S.; Wiegand, K.C.; Melnyk, N.; Chow, C.; Salamanca, C.; Prentice, L.M.; Senz, J.; Yang, W.N.; Spillman, M.A.; Cochrane, D.R.; et al. Type-Specific Cell Line Models for Type-Specific Ovarian Cancer Research. PLoS ONE 2013, 8, e72162. [Google Scholar] [CrossRef]
- Ikediobi, O.N.; Davies, H.; Bignell, G.; Edkins, S.; Stevens, C.; O’Meara, S.; Santarius, T.; Avis, T.; Barthorpe, S.; Brackenbury, L.; et al. Mutation analysis of 24 known cancer genes in the NCI-60 cell line set. Mol. Cancer Ther. 2006, 5, 2606–2612. [Google Scholar] [CrossRef] [PubMed]
- Lambrinakos, A.; Yakubovskaya, M.; Babon, J.J.; Neschastnova, A.A.; Vishnevskaya, Y.V.; Belitsky, G.A.; D’Cunha, G.; Horaitis, O.; Cotton, R.G.H. Novel TP53 gene mutations in tumors of Russian patients with breast cancer detected using a new solid phase chemical cleavage of mismatch method and identified by sequencing. Hum. Mutat. 2004, 23, 186–192. [Google Scholar] [CrossRef] [PubMed]
- Liliac, L.; Carcangiu, M.L.; Canevari, S.; Caruntu, I.D.; Apostol, D.G.C.; Danciu, M.; Onofriescu, M.; Amalinei, C. The value of PAX8 and WT1 molecules in ovarian cancer diagnosis. Rom. J. Morphol. Embryol. 2013, 54, 17–27. [Google Scholar] [PubMed]
- Zhao, L.C.; Quo, M.; Sneige, N.; Gong, Y. Value of PAX8 and WT1 Immunostaining in Confirming the Ovarian Origin of Metastatic Carcinoma in Serous Effusion Specimens. Am. J. Clin. Pathol. 2012, 137, 304–309. [Google Scholar] [CrossRef] [PubMed]
- Kurman, R.J.; Shih, I.M. The Origin and Pathogenesis of Epithelial Ovarian Cancer: A Proposed Unifying Theory. Am. J. Surg. Pathol. 2010, 34, 433–443. [Google Scholar] [CrossRef] [PubMed]
- Nonaka, D.; Chiriboga, L.; Soslow, R.A. Expression of Pax8 as a useful marker in distinguishing ovarian carcinomas from mammary carcinomas. Am. J. Surg. Pathol. 2008, 32, 1566–1571. [Google Scholar] [CrossRef] [PubMed]
- Ince, T.A.; Sousa, A.D.; Jones, M.A.; Harrell, J.C.; Agoston, E.S.; Krohn, M.; Selfors, L.M.; Liu, W.B.; Chen, K.; Yong, M.; et al. Characterization of twenty-five ovarian tumour cell lines that phenocopy primary tumours. Nat. Commun. 2015, 6, 1–14. [Google Scholar] [CrossRef] [PubMed]
- Hew, K.E.; Miller, P.C.; El-Ashry, D.; Sun, J.; Besser, A.H.; Ince, T.A.; Gu, M.N.; Wei, Z.; Zhang, G.; Brafford, P.; et al. MAPK Activation Predicts Poor Outcome and the MEK Inhibitor, Selumetinib, Reverses Antiestrogen Resistance in ER-Positive High-Grade Serous Ovarian Cancer. Clin. Cancer Res. 2016, 22, 935–947. [Google Scholar] [CrossRef] [PubMed]
- Lupia, M.; Cavallaro, U. Ovarian cancer stem cells: Still an elusive entity? Mol. Cancer 2017, 16, 64. [Google Scholar] [CrossRef] [PubMed]
- Klemba, A.; Purzycka-Olewiecka, J.K.; Wcisło, G.; Czarnecka, A.M.; Lewicki, S.; Lesyng, B.; Szczylik, C.; Kieda, C. Surface markers of cancer stem-like cells of ovarian cancer and their clinical relevance. Contemp. Oncol. (Pozn.) 2018, 22, 48–55. [Google Scholar] [CrossRef] [PubMed]
- Steg, A.D.; Bevis, K.S.; Katre, A.A.; Ziebarth, A.; Dobbin, Z.C.; Alvarez, R.D.; Zhang, K.; Conner, M.; Landen, C.N. Stem Cell Pathways Contribute to Clinical Chemoresistance in Ovarian Cancer. Clin. Cancer Res. 2012, 18, 869–881. [Google Scholar] [CrossRef] [PubMed]
- Latifi, A.; Abubaker, K.; Castrechini, N.; Ward, A.C.; Liongue, C.; Dobill, F.; Kumar, J.; Thompson, E.W.; Quinn, M.A.; Findlay, J.K.; et al. Cisplatin Treatment of Primary and Metastatic Epithelial Ovarian Carcinomas Generates Residual Cells With Mesenchymal Stem Cell-Like Profile. J. Cell. Biochem. 2011, 112, 2850–2864. [Google Scholar] [CrossRef] [PubMed]
- Broadley, K.W.R.; Hunn, M.K.; Farrand, K.J.; Price, K.M.; Grasso, C.; Miller, R.J.; Hermans, I.F.; McConnell, M.J. Side Population is Not Necessary or Sufficient for a Cancer Stem Cell Phenotype in Glioblastoma Multiforme. Stem Cells 2011, 29, 452–461. [Google Scholar] [CrossRef] [PubMed]
- Zdzalik, D.G.P.; Lipner, J.; Bujak, A.; Dymek, B.; Gunerka, P.; Stanczak, A.; Lamparska-Przybysz, M.; Wieczorek, M.; Dzwonek, K. Design and development of active and selective FGFR kinase inhibitor CPL-043 as potential anticancer targeted therapy. In Proceedings of the European Cancer Congress, Amstedram, The Netherlands, 27 September–1 October 2013. [Google Scholar]
- Lisowska, K.M.; Olbryt, M.; Student, S.; Kujawa, K.A.; Cortez, A.J.; Simek, K.; Dansonka-Mieszkowska, A.; Rzepecka, I.K.; Tudrej, P.; Kupryjanczyk, J. Unsupervised analysis reveals two molecular subgroups of serous ovarian cancer with distinct gene expression profiles and survival. J. Cancer Res. Clin. 2016, 142, 1239–1252. [Google Scholar] [CrossRef] [PubMed]
- Fogh, J.; Trempe, G. New Human Tumor Cell Lines. In Human Tumor Cells In Vitro; Fogh, J., Ed.; Springer: Boston, MA, USA, 1975; pp. 115–159. [Google Scholar]
- Hamilton, T.C.; Young, R.C.; Ozols, R.F. Experimental-Model Systems of Ovarian-Cancer—Applications to the Design and Evaluation of New Treatment Approaches. Semin. Oncol. 1984, 11, 285–298. [Google Scholar] [PubMed]
- Shaw, T.J.; Senterman, M.K.; Dawson, K.; Crane, C.A.; Vanderhyden, B.C. Characterization of intraperitoneal, orthotopic, and metastatic xenograft models of human ovarian cancer. Mol. Ther. 2004, 10, 1032–1042. [Google Scholar] [CrossRef] [PubMed]
- Lau, D.H.M.; Lewis, A.D.; Ehsan, M.N.; Sikic, B.I. Multifactorial Mechanisms Associated with Broad Cross-Resistance of Ovarian-Carcinoma Cells Selected by Cyanomorpholino Doxorubicin. Cancer Res. 1991, 51, 5181–5187. [Google Scholar] [PubMed]
- Wilson, A.P. Characterization of a Cell-Line Derived from the Ascites of a Patient with Papillary Serous Cystadenocarcinoma of the Ovary. J. Natl. Cancer Inst 1984, 72, 513–521. [Google Scholar] [PubMed]
- Elias, K.M.; Emori, M.M.; Papp, E.; MacDuffie, E.; Konecny, G.E.; Velculescu, V.E.; Drapkin, R. Beyond genomics: Critical evaluation of cell line utility for ovarian cancer research. Gynecol. Oncol. 2015, 139, 97–103. [Google Scholar] [CrossRef] [PubMed]
- Itamochi, H.; Kigawa, J. Clinical trials and future potential of targeted therapy for ovarian cancer. Int. J. Clin. Oncol. 2012, 17, 430–440. [Google Scholar] [CrossRef] [PubMed]
- Cortez, A.J.; Tudrej, P.; Kujawa, K.A.; Lisowska, K.M. Advances in ovarian cancer therapy. Cancer Chemoth. Pharm. 2018, 81, 17–38. [Google Scholar] [CrossRef] [PubMed]
- Witt, A.E.; Lee, C.W.; Lee, T.I.; Azzam, D.J.; Wang, B.; Caslini, C.; Petrocca, F.; Grosso, J.; Jones, M.; Cohick, E.B.; et al. Identification of a cancer stem cell-specific function for the histone deacetylases, HDAC1 and HDAC7, in breast and ovarian cancer. Oncogene 2017, 36, 1707–1720. [Google Scholar] [CrossRef] [PubMed]
- Uphoff, C.C.; Denkmann, S.A.; Steube, K.G.; Drexler, H.G. Detection of EBV, HBV, HCV, HIV-1, HTLV-I and-II, and SMRV in Human and Other Primate Cell Lines. J. Biomed. Biotechnol. 2010, 2010, 1–23. [Google Scholar] [CrossRef] [PubMed]
- Howe, B.; Umrigar, A.; Tsien, F. Chromosome Preparation from Cultured Cells. JoVE J. Vis. Exp. 2014, 83, 1–5. [Google Scholar] [CrossRef] [PubMed]
- Brozek, I.; Cybulska, C.; Ratajska, M.; Piatkowska, M.; Kluska, A.; Balabas, A.; Dabrowska, M.; Nowakowska, D.; Niwinska, A.; Pamula-Pilat, J.; et al. Prevalence of the most frequent BRCA1 mutations in Polish population. J. Appl. Genet. 2011, 52, 325–330. [Google Scholar] [CrossRef] [PubMed]
- Krzesniak, M.; Butkiewicz, D.; Rachtan, J.; Matuszczyk, I.; Grzybowska, E.; Rusin, M. A novel germline TP53 mutation p.Pro190Arg detected in a patient with lung and bilateral breast cancers. Adv. Med. Sci. Pol. 2017, 62, 207–210. [Google Scholar] [CrossRef] [PubMed]

| Loci | Results |
|---|---|
| AMELO (amelogenin) | X |
| D10S1248 | 14, 15 |
| vWA (40th intron of von Willebrand Factor gene) | 14 |
| D16S539 | 12, 14 |
| D2S1338 | 21, 25 |
| D8S1179 | 11, 14 |
| D21S11 | 29, 30 |
| D18S51 | 12 |
| D22S1045 | 15 |
| D19S43 | 13, 15 |
| THO1 (1st intron of tyrosine hydroylase gene) | 8 |
| FGA (3rd intron of alpha fibrinogen gene) | 22, 25 |
| D2S441 | ?, 14 |
| D3S1358 | 15 |
| D1S1656 | 15 |
| D12S391 | 21 |
| Cell Line | Agent | IC50 (µM) |
|---|---|---|
| OVPA8 | Cisplatin | 16.27 |
| Paclitaxel | 0.001 | |
| CPL304-110-01 | 3.05 | |
| AZD4547 | >10 | |
| SKOV3 | Cisplatin | 3.17 |
| Paclitaxel | 0.0055 | |
| CPL304-110-01 | 0.99 | |
| AZD4547 | 7.67 | |
| OVCAR3 | Cisplatin | 1.48 |
| Paclitaxel | <0.0016 | |
| CPL304-110-01 | >10.00 | |
| AZD4547 | >10.00 | |
| OAW42 | Cisplatin | 2.78 |
| Paclitaxel | 0.0033 | |
| CPL304-110-01 | 3.51 | |
| AZD4547 | >10.00 | |
| ES2 | Cisplatin | 1.63 |
| Paclitaxel | <0.0016 | |
| CPL304-110-01 | 2.32 | |
| AZD4547 | >10 | |
| A2780 | Cisplatin | 1.03 |
| Paclitaxel | 0.004 | |
| CPL304-110-01 | 1.65 | |
| AZD4547 | 9.73 |
| Target | Sequences of Primers (5′→3′) | Amplicon Size | Annealing Temperature |
|---|---|---|---|
| HBV (hepatitis B virus) | F: 5′-AAGCTGTGCCTTGGGTGGCTTTG-3′ | 570 bp | 58 °C |
| R: 5′-CGAGATTGAGATCTTCTGCGACG-3′ | |||
| HCV (hepatitis C virus) | F: 5′-GCCATGGCGTTAGTATGAGTGTC-3′ | 259 bp | 58 °C |
| R: 5′-ATGCACGGTCTACGAGACCTCC-3′ | |||
| HIV (human immunodeficiency virus) | F: 5′-ATAATCCACCTATCCCAGTAGGAGAAAT-3′ | 116 bp | 58 °C |
| R: 5′-TTTGGTCCTTGTCTTATGTCCAGAATGC-3′ | |||
| B2M (β-2-microglobulin) | F: 5′-CTGGGTTTCATCCATCCGACA-3′ | 212 bp | 59 °C |
| R: 5′-GTCTCGATCCCACTTAACTATCTTGG-3′ | |||
| BNIP3 (BCL2-interacting protein 3) | F: 5′-CGGATTGGGGATCTATATTGGAAG- 3′ | 187 bp | 59 °C |
| R: 5′-AGGAACGCAGCATTTACAGAACAA-3′ | |||
| Mycoplasma | F: 5′-GGCGAATGGGTGAGTAACACG-3′ | 500 bp | 55 °C |
| R: 5′-CGGATAACGCTTGCGACCTAT-3′ | |||
| 18S rRNA (18S ribosomal RNA) | F: 5′-CATGGCCGTTCTTAGTTGGTG-3′ | 193 bp | 55 °C |
| R: 5′-GTGCAGCCCCGGACATCTAA-3′ |
| Target | Sequences of Primers (5′→3′) | Annealing Temperature |
|---|---|---|
| BRCA1: C61G (c.181T>G; p.Cys61Gly) | F: 5′-CTCTTAAGGGCAGTTGTGAG-3′ | 65 °C |
| R: 5′-TTCCTACTGTGGTTGCTTCC-3′ | ||
| BRCA1: 4153delA (c.4035delA; p.Glu1346Lysfs) | F: 5′-TATTGGCAAAGGCATCTCAG-3′ | 65 °C |
| R: 5′-GCCAAAGATGACGTCCTAGC-3′ | ||
| DEL: 5′-GGAATTGGTTTCAGATGATGAG-3′ | ||
| BRCA1: 5382insC (c.5266dupC; p.Gln1756Profs) | F: 5′-ATATGACGTGTCTGCTCCAC-3′ | 65 °C |
| RINS: 5′-CCTTTCTGTCCTGGGGATT-3′ | ||
| R: 5′-GGGAATCCAAATTACACAGC-3′ | ||
| TP53 (exones 5–6) | F: 5′-GTTGCAGGAGGTGCTTACA-3′ | 61 °C |
| R: 5′-GAGGTCAAATAAGCAGCAGG-3′ | ||
| TP53 (exones 7–9) | F: 5′-GAGCGAGATTCCATCTCAA-3′ | 53 °C |
| R: 5′-CAGTGCTAGGAAAGAGGCAA-3′ |
| Target | Sequences of Primers (5′→3′) | Amplicon Size | Annealing Temperature |
|---|---|---|---|
| FN1 | F: 5′-CAACTCTGTCAACGAAGGCTTG-3′ | 493 bp | 59 °C |
| R: 5′-CTGAGAATACTGGTTGTAGGACTGG-3′ | |||
| POSTN | F: 5′-CTATCCAGCAGACACACCTGTTG-3′ | 347 bp | 51 °C |
| R: 5′-TTTCCACAGGCACTCCATCAAT-3′ | |||
| 18S rRNA | F: 5′-CATGGCCGTTCTTAGTTGGTG-3′ | 193 bp | 55 °C |
| R: 5′-GTGCAGCCCCGGACATCTAA-3′ |
© 2018 by the authors. Licensee MDPI, Basel, Switzerland. This article is an open access article distributed under the terms and conditions of the Creative Commons Attribution (CC BY) license (http://creativecommons.org/licenses/by/4.0/).
Share and Cite
Tudrej, P.; Olbryt, M.; Zembala-Nożyńska, E.; Kujawa, K.A.; Cortez, A.J.; Fiszer-Kierzkowska, A.; Pigłowski, W.; Nikiel, B.; Głowala-Kosińska, M.; Bartkowska-Chrobok, A.; et al. Establishment and Characterization of the Novel High-Grade Serous Ovarian Cancer Cell Line OVPA8. Int. J. Mol. Sci. 2018, 19, 2080. https://doi.org/10.3390/ijms19072080
Tudrej P, Olbryt M, Zembala-Nożyńska E, Kujawa KA, Cortez AJ, Fiszer-Kierzkowska A, Pigłowski W, Nikiel B, Głowala-Kosińska M, Bartkowska-Chrobok A, et al. Establishment and Characterization of the Novel High-Grade Serous Ovarian Cancer Cell Line OVPA8. International Journal of Molecular Sciences. 2018; 19(7):2080. https://doi.org/10.3390/ijms19072080
Chicago/Turabian StyleTudrej, Patrycja, Magdalena Olbryt, Ewa Zembala-Nożyńska, Katarzyna A. Kujawa, Alexander J. Cortez, Anna Fiszer-Kierzkowska, Wojciech Pigłowski, Barbara Nikiel, Magdalena Głowala-Kosińska, Aleksandra Bartkowska-Chrobok, and et al. 2018. "Establishment and Characterization of the Novel High-Grade Serous Ovarian Cancer Cell Line OVPA8" International Journal of Molecular Sciences 19, no. 7: 2080. https://doi.org/10.3390/ijms19072080
APA StyleTudrej, P., Olbryt, M., Zembala-Nożyńska, E., Kujawa, K. A., Cortez, A. J., Fiszer-Kierzkowska, A., Pigłowski, W., Nikiel, B., Głowala-Kosińska, M., Bartkowska-Chrobok, A., Smagur, A., Fidyk, W., & Lisowska, K. M. (2018). Establishment and Characterization of the Novel High-Grade Serous Ovarian Cancer Cell Line OVPA8. International Journal of Molecular Sciences, 19(7), 2080. https://doi.org/10.3390/ijms19072080






